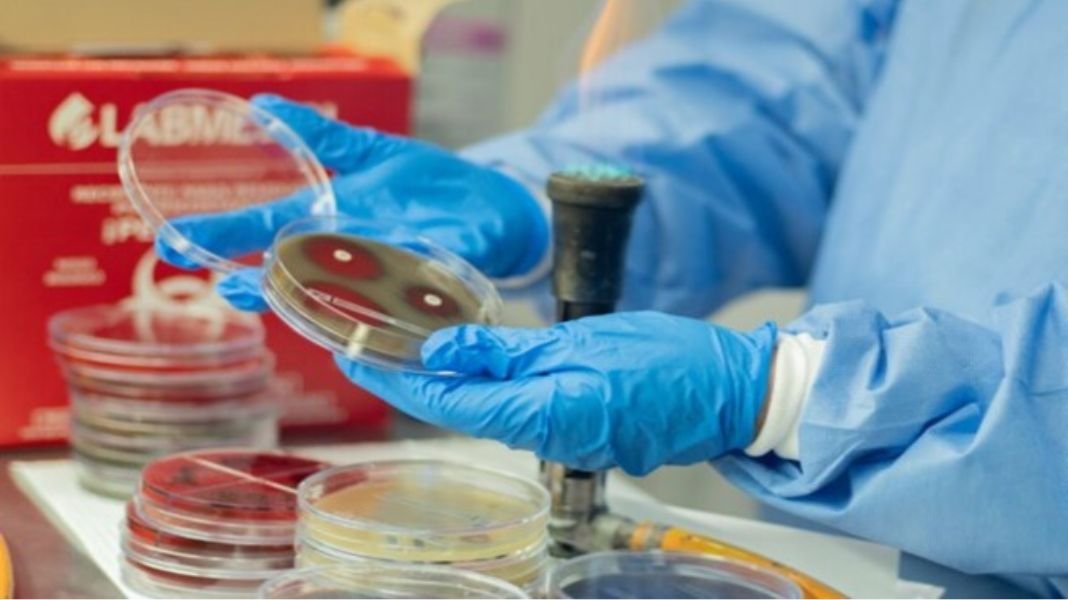
Minsa se suma a la Semana Mundial de Concientización sobre la Resistencia a los Antimicrobianos

Minsa se suma a la Semana Mundial de Concientización sobre la Resistencia a los Antimicrobianos
Es una campaña mundial que se busca concientizar a la población sobre el uso responsable de estos medicamentos
Del 18 al 24 de noviembre, el Ministerio de Salud (Minsa), a través del Instituto Nacional de Salud (INS), participa activamente en la Semana Mundial de Concientización sobre la Resistencia a los Antimicrobianos, una campaña mundial que busca sensibilizar a la población sobre esta creciente amenaza que pone en riesgo a la eficacia de los tratamientos y la seguridad sanitaria en todo el mundo.
En esa línea con su compromiso con la salud pública, el INS desarrollará diversas actividades, entre ellas un webinar, la difusión de videos informativos en sus plataformas institucionales, entre otros. Estas acciones están orientadas a educar a la sociedad sobre los riesgos que implica el uso inapropiado de antimicrobianos, y la necesidad urgente de adoptar prácticas responsables tanto en el ámbito médico como en la vida cotidiana.
RESISTENCIA A LOS ANTIMICROBIANOS: UN DESAFÍO CRECIENTE PARA LA SALUD MUNDIAL
Los antimicrobianos (antibióticos, antivirales, antifúngicos y antiparasitarios) son fundamentales para prevenir y tratar una amplia gama de infecciones. Sin embargo, su uso excesivo o incorrecto está llevando a la aparición de cepas de microorganismos resistentes (bacterias, virus, hongos y parásitos), dificultando el tratamiento de enfermedades que antes eran controlables y elevando el riesgo de complicaciones graves y muertes.
“La resistencia a los antimicrobianos no es solo un problema de los profesionales de la salud, es una responsabilidad compartida entre todos. El uso adecuado de estos medicamentos es crucial para evitar que las infecciones comunes se conviertan en amenazas difíciles de controlar”, señaló el médico infectólogo del INS, Roger Araujo.
ACCIÓN MULTISECTORIAL COMO RESPUESTA EFECTIVA
El INS reafirma su compromiso con la implementación de políticas públicas que promuevan el uso racional de antimicrobianos y trabajen en la prevención de infecciones resistentes.
Desde 2016, el Minsa y el INS han impulsado la elaboración del Plan Multisectorial para el Enfrentamiento de la Resistencia a los Antimicrobianos, aprobado mediante el Decreto Supremo n.º 010-2019-SA, y que dio lugar a la creación de una Comisión Multisectorial de Naturaleza Permanente, donde el INS ejerce la secretaría técnica.
Esta comisión tiene como objetivo coordinar las acciones necesarias para hacer frente a la amenaza de la resistencia antimicrobiana, protegiendo tanto a las personas como a los ecosistemas de los efectos adversos del uso indebido de antimicrobianos.
¡ACTÚA AHORA!
Este 18 de noviembre, el INS invita a la ciudadanía a unirse a la campaña global, a informarse y a tomar conciencia sobre cómo sus decisiones en el uso de medicamentos pueden tener un impacto en la lucha contra la resistencia antimicrobiana.
El INS destaca la importancia de seguir siempre las indicaciones médicas al utilizar antibióticos y otros antimicrobianos, evitando la automedicación y promoviendo una cultura de prevención y cuidado responsable.







Thanks for sharing. I read many of your blog posts, cool, your blog is very good. https://www.binance.info/fr/register?ref=T7KCZASX
References:
Oceans 11 casino https://pad.stuve.uni-ulm.de/s/K_Mkru4Em